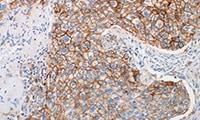
NSCLC Online Atlas of Stains teaser image
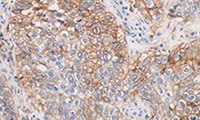
NSCLC e-Learning teaser image

e-Learning programs for pharmDx products are designed to quickly provide laboratory technicians, pathologists and scientists worldwide with accurate information on how to achieve reliable results using Agilent's products.
PD-L1 IHC 22C3 pharmDx
PD-L1 IHC 28-8 pharmDx